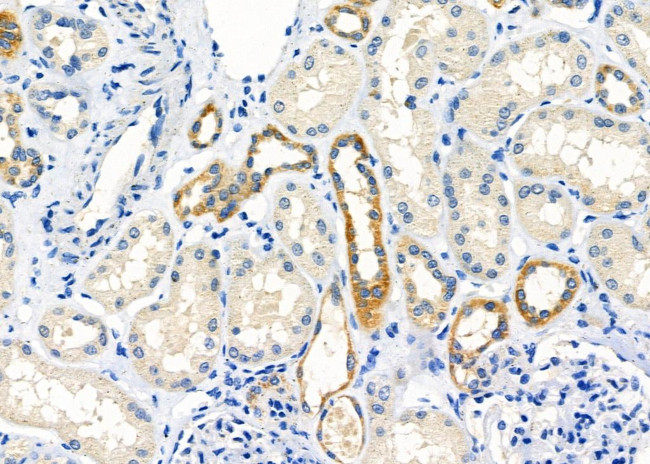
STAM2 Antibody in Immunohistochemistry (Paraffin) (IHC (P))

Search
Invitrogen
STAM2 Polyclonal Antibody
{{$productOrderCtrl.translations['antibody.pdp.commerceCard.promotion.promotions']}}
{{$productOrderCtrl.translations['antibody.pdp.commerceCard.promotion.viewpromo']}}
{{$productOrderCtrl.translations['antibody.pdp.commerceCard.promotion.promocode']}}: {{promo.promoCode}} {{promo.promoTitle}} {{promo.promoDescription}}. {{$productOrderCtrl.translations['antibody.pdp.commerceCard.promotion.learnmore']}}
图: 1 / 8
STAM2 Antibody (PA5-99721) in IHC (P)








产品信息
PA5-99721
种属反应
宿主/亚型
分类
类型
抗原
偶联物
形式
浓度
规格
纯化类型
保存液
内含物
保存条件
运输条件
RRID
产品详细信息
Antibody detects endogenous levels of total STAM2.
靶标信息
The protein encoded by this gene is closely related to STAM, an adaptor protein involved in the downstream signaling of cytokine receptors, both of which contain a SH3 domain and the immunoreceptor tyrosine-based activation motif (ITAM). Similar to STAM, this protein acts downstream of JAK kinases, and is phosphorylated in response to cytokine stimulation. This protein and STAM thus are thought to exhibit compensatory effects on the signaling pathway downstream of JAK kinases upon cytokine stimulation.
仅用于科研。不用于诊断过程。未经明确授权不得转售。
篇参考文献 (0)
生物信息学
蛋白别名: DKFZp564C047; HGNC:11358; Hrs binding protein; Hrs-binding protein; HSE1 homolog; Signal transducing adapter molecule 2; signal transducing adaptor molecule (SH3 domain and ITAM motif) 2; STAM-2; STAM-like protein containing an SH3 domain; STAM-like protein containing SH3 and ITAM domains; STAM-like protein containing SH3 and ITAM domains 2; unnamed protein product
基因别名: 1200004O12Rik; 5730456G07Rik; BB145015; HBP; STAM2; STAM2A; STAM2B
UniProt ID: (Human) O75886, (Rat) Q5XHY7, (Mouse) O88811
Entrez Gene ID: (Human) 10254, (Rat) 311030, (Mouse) 56324